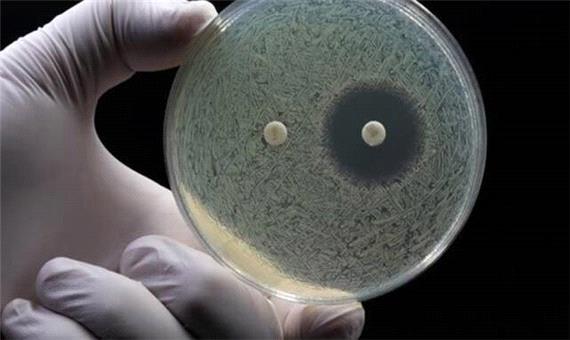

وعده هوشمصنوعی برای نبرد با مقاومت آنتیبیوتیکی
نکات خواندني
بزرگنمايي:


سیاست و بازاریابی - ایسنا / پژوهشگران با بهرهگیری از هوش مصنوعی و فناوری نانو، روشی نوین برای طراحی و رسانش پپتیدهای ضدمیکروبی ارائه کردهاند؛ روشی که میتواند به درمان مؤثرتر عفونتها، مقابله با بحران جهانی مقاومت آنتیبیوتیکی و حتی کاربردهای گسترده در کشاورزی و صنایع غذایی منجر شود.
به نقل از ستاد نانو، این تیمهای پژوهشی با استفاده از مدلهای زبانی پروتئین و یادگیری تقویتی موفق شدند در مدت کمتر از دو هفته، پپتیدهایی با توان بالا و پایداری چشمگیر تولید کنند که در برابر باکتریهای مقاوم به دارو عملکردی بیسابقه نشان دادهاند. علاوه بر این، نانوساختارهای هوشمند طراحیشده در قالب هیدروژلها و کمپلکسهای فلزیـپپتیدی، امکان رهایش کنترلشده و اثر همزمان ضدباکتریایی و ترمیم زخم را فراهم کردهاند. این دستاورد، نقطه عطفی در داروسازی و زیستفناوری به شمار میآید.
بازار ![]()
در حالی که نگرانی جهانی از گسترش مقاومت آنتیبیوتیکی به اوج رسیده است، پژوهشگران در چین با تلفیق هوش مصنوعی و نانو، مسیر تازهای را برای طراحی، بهینهسازی و رسانش پپتیدهای ضدمیکروبی (AMPs) گشودهاند. این مولکولهای کوچک پروتئینی که بهطور طبیعی در بدن موجودات زنده برای مقابله با عفونتها تولید میشوند، بهعنوان جایگزین بالقوه آنتیبیوتیکها شناخته میشوند، اما تاکنون به دلیل سمیت، ناپایداری و سازوکارهای ناشناخته، کاربرد بالینی محدودی داشتهاند.
در مقالهای تازه با عنوان «بهرهگیری از نوآوریها در طراحی پپتیدهای ضدمیکروبی: از کشف مبتنی بر هوش مصنوعی تا سازوکارهای هدفگیری دقیق» که در نشریه Food & Medicine Homology منتشر شده است، گروهی از پژوهشگران از دانشگاه چجیانگ (Zhejiang University)، دانشگاه صنعتی دالیان (Dalian University of Technology)، دانشگاه اقیانوس چین (Ocean University of China)، آکادمی علوم چین (Chinese Academy of Sciences) و دانشگاه علوم پزشکی گویژو (Guizhou Medical University) دستاوردهای خود را در این زمینه تشریح کردند.
به گفته دکتر «جین ژانگ» (Jin Zhang)، استاد دانشگاه گویژو و نویسنده مسئول مقاله، «چارچوبهای طراحی مبتنی بر هوش مصنوعی میتوانند در عرض چند روز، پپتیدهای بسیار کارآمدی تولید کنند و بدینترتیب زمان توسعه داروها را بهطور چشمگیری کاهش دهند. آیندهای را پیشِ رو داریم که در آن میتوان پپتیدهایی با عملکردهای دقیق و هدفمند طراحی کرد؛ از نابودی پاتوژنها گرفته تا تحریک ایمنی یا ترمیم بافتها.»
در یکی از پژوهشهای شاخص، تیم دانشگاه چجیانگ با ترکیب مدلهای زبانی پروتئین و یادگیری تقویتی، توانست در مدت تنها یازده روز، هجده پپتید ضدمیکروبی با عملکرد گسترده طراحی کند. این ترکیبات در آزمایشهای درونکشتگاهی، اثربخشی قابلتوجهی در غلظتهای بسیار پایین نشان دادند و در آزمایشهای متوالی، نشانهای از ایجاد مقاومت مشاهده نشد.
در دانشگاه گویژو نیز سامانهای برای طراحی منطقی پپتیدهای ضدقارچی توسعه یافته است که با استفاده از یادگیری ماشین و بهینهسازی چندهدفه، پپتیدهایی را پیشبینی میکند که هم غشای قارچ را تخریب کرده و هم عملکرد میتوکندری را مختل میسازند. به گفته دکتر ژانگ، «این سازوکار دوگانه احتمال شکلگیری مقاومت را بهشدت کاهش میدهد.»
از سوی دیگر، فناوری نانو در زمینه رسانش هدفمند پپتیدها نقشی اساسی ایفا کرده است. محققان آکادمی علوم چین، نوعی هیدروژل حساس به آنزیم طراحی کردهاند که میتواند در محل عفونت، پپتیدها را بهصورت هوشمند و تدریجی آزاد کند. همچنین تیمی از دانشگاه فوزو (Fuzhou University) کمپلکسهای فلزیـپپتیدی را توسعه دادهاند که با تولید گونههای فعال اکسیژن، علاوه بر نابودی باکتریها، به تسریع روند ترمیم زخم نیز کمک میکند.
کاربردهای بالقوه این پپتیدها تنها به پزشکی محدود نیست. پژوهشگران به بررسی استفاده از آنها بهعنوان آفتکشهای زیستپایه در کشاورزی و نگهدارندههای طبیعی در صنایع غذایی نیز پرداختهاند. دکتر «نینگشیان یانگ» (Ning-Xian Yang)، استاد دانشگاه گویژو و نویسنده اول مقاله میگوید: «چندمنظوره بودن پپتیدها، آنها را به گزینهای ایدهآل برای راهحلهای پایدار در بخشهای مختلف از سلامت تا غذا تبدیل کرده است.»
پژوهشگران معتقدند آینده این حوزه در گرو همافزایی هوش مصنوعی، زیستشناسی ترکیبی، فناوریهای چنداُمیک و مواد هوشمند است تا پایداری، هزینه و نظارت بر مقاومت بهینه شود. دکتر یانگ میافزاید: «هدف نهایی ما تولید کمهزینه، افزایش پایداری و پایش بلندمدت مقاومت است تا بتوان این فناوری را به درمانهای ایمن، مؤثر و در دسترس برای همه تبدیل کرد.»
این دستاورد، نهتنها گامی رو به جلو در توسعه داروهای نوین است، بلکه نشان میدهد همگرایی میان علوم داده و نانوفناوری میتواند پایهگذار عصر تازهای در پزشکی، کشاورزی و صنایع غذایی باشد.

لینک کوتاه:
https://www.siasatvabazaryabi.ir/Fa/News/786050/